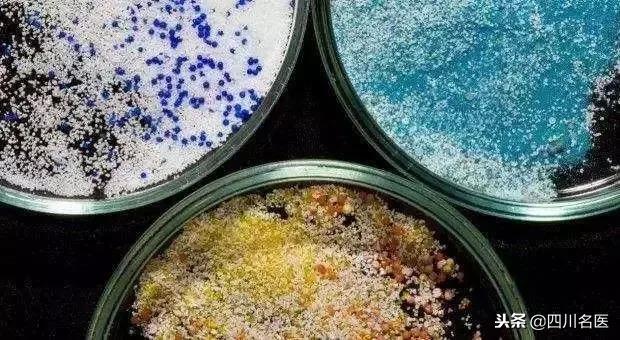
人体内有什么可怕的东西,塑料对肝脏有害吗

最近,一项研究发现,全球50%的人口体内可能都有微塑料。
这是什么概念?可能你我的体内都有微塑料!

有研究揭示:人体内的微塑料可从内脏转移到血液、淋巴系统甚至肝脏,严重甚至可致癌。
到底是怎么回事?
01:什么是微型塑料?
微塑料是指直径小于5毫米的塑料碎片,这一概念是2004年由英国的科研人员首次提出来的,微塑料有片状、线状或块状等很多形态,它由于体积小,肉眼常难以辨别。
依据微塑料来源,可分为原生和次生微塑料。

原生微塑料指是在制造出来时,就是直径小于 5 毫米的塑胶颗粒,如牙膏、磨砂洗面奶等日用品中的柔珠。
次生的微塑料是指那些暴露在外界的塑料垃圾,由于普通的塑料无法生物降解,只会碎裂成更小的塑料碎片。

近日,欧洲联合胃肠病学周发布了一项新研究,首次确认:在人体内发现了多达9种不同种类的微塑料,平均每10克粪便中就含有约20个微塑料颗粒。
据研究人员菲利普·施沃布尔估计,全球50%的人口体内都有微塑料。
02:吃进人体的塑料从何而来?
那么,吃进的塑料从何而来呢?令人担忧的是,据以下众多研究显示,微塑料已经无处不在,而且人类一直在摄入。
鱼类

一份来自新西兰奥克兰大学的报告发现,经过长期调研发现,市面上常见的9种可以商业捕捞的鱼中,有8种鱼曾经常性地食用塑料元素。
食盐

《环境科学与技术》杂志上的一项最新研究发现,全球销售的食盐品牌中,超过90%都被塑料污染。其中亚洲品牌的密度尤其高,是塑料污染的高发区。
瓶装水

美国纽约州立大学人员曾做过一项研究,他们选取了250瓶来自9个国家、11个知名品牌的瓶装水进行检测,结果发现仅有17瓶水中没有塑料微粒,这些细小的微粒平均每公升水中含有314个。
贝类

今年6月,一份由英国赫尔大学与布鲁内尔伦敦大学共同发表的研究表明,在英国市场上出售的青口贝,全部发现了微塑料颗粒。平均每100克贻贝,就有70个微塑料颗粒。而且,野生贻贝微塑料含量通常比养殖贻贝要多。
啤酒、蜂蜜

研究人员发现德国的啤酒中每升的微塑料含量高达150个,蜂蜜中每千克最高达400个。
呼吸

据零废弃联盟政策顾问毛达博士介绍,除了饮食,日常的呼吸也是微塑料的摄入途经。衣物、房间里铺的地毯等大部分是由化纤制成的。衣物摩擦或走在地毯上时,就会释放出微纤维进而形成微塑料。
03:微塑料进入人体有什么危害?
微塑料进入人体,到底有什么危害呢?
微塑料对人体的危害主要来源于两大部分,一是因为微塑料会吸附很多有害物质,二是因为微塑料能进一步分解为更小的微粒,进入人体循环系统。
有研究发现,微塑料中含有许多持久性有机污染物,它们具有高毒性和生物积累性,能够通过生物链进入到人体,在低浓度时也会对生物体造成伤害。
此外,当微塑料进入人体后,可能会被分解为更小的微粒,从内脏转移到血液、淋巴系统甚至肝脏,肠道中的微塑料也可能影响消化系统的免疫反应。

据果壳网介绍,当微塑料转移到血液中时,可能会导致血栓。当微塑料到达肺部时,可能会导致癌症以及其他疾病。
“当浓度足够的时候,这些化学物质能伤害甚至杀死细胞。细胞可能会被成功替代,蛋白质及DNA都可能受到伤害。”伦敦国王学院教授弗兰克·凯里称。
04:呼吁!少用塑料制品
考虑到环保问题,从11月起,麦当劳将在北京10家试点餐厅使用“免吸管杯盖”并不主动提供吸管。星巴克也在7月宣布,2020年之前全球所有分店禁用塑胶吸管,同时公布不用吸管的新杯盖设计。

我们每个人都是塑料垃圾的制造者,只是大家可能没有想到,平时无意间丢的垃圾,在大自然的循环下,又悄无声息地爬上了你的餐桌,而人类,最终只能自食其果……
为了家人的幸福,也为了给子孙后代留下一个良好的生态环境,小康妹儿在此呼吁,平时少用塑料制品,切勿随意丢弃垃圾!

看完记得转发给家人噢,让更多人树立起保护环境的意识!
文章来源:健康日报、科技日报、果壳网等
图片来源:123rf、人民日报等
编辑:离离